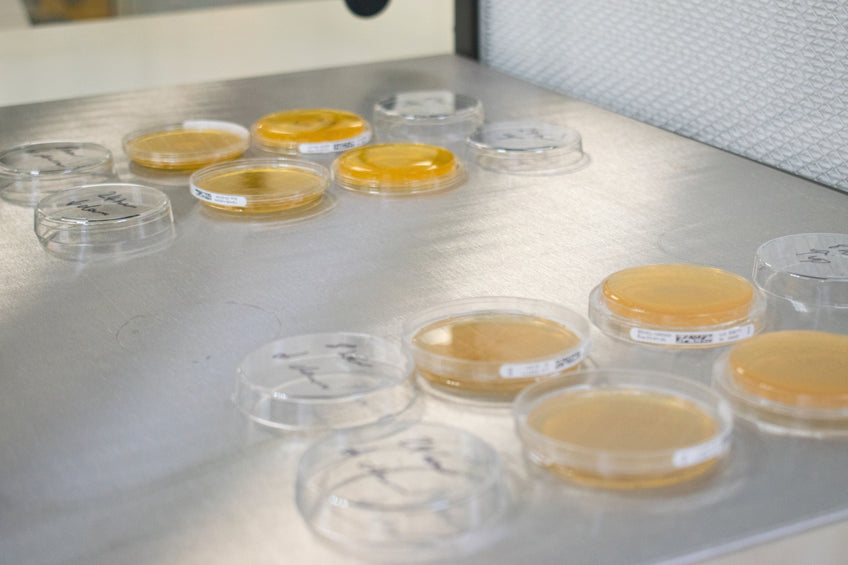

Laminar Flow Hood Cleaning Procedure

A laminar flow hood creates a clean environment for working with sensitive samples, such as biological cultures. Within the hood, HEPA filters ensure that most of the air entering your system is free from particles and contamination. However, there are still some ways by which your workspace can be compromised. Regular and thorough cleaning of your laminar flow hood allows you to reliably conduct your experiments without risk of contamination.
UV Sterilization
UV sterilization is a method used to kill microorganisms. Exposure to UV light alters the genes of harmful microbes, making them inactive. Therefore, UV lights are a common feature in equipment like PCR cabinets, many biological safety cabinets, and our laminar flow hoods. Some advanced clean rooms even use UV lights throughout the whole room.
Importantly, prolonged exposure to UV wavelengths can be harmful to humans. As a safety measure, workspaces should only be exposed to UV light to prepare them for sterile work. The light should always be turned off during workspace use. To prioritize user safety, the Ossila Laminar Flow Hood is designed to automatically switch off the UV light when someone approaches. The UV light is only reactivated if motion has not been detected for 30 seconds. A warning light ensures you are always aware of the UV light status.
Preparing and Cleaning Your Laminar Flow Hood
Sources of Contamination
The primary sources of contamination in your laminar flow hood are:
- Contamination that has accumulated on the work bench
- Airborne contamination that has entered through the front panel
- The surfaces of equipment and materials you bring into the laminar flow hood (bottles, vials, etc)
Cleaning Procedure
To clean your laminar flow hood, we recommend following specific steps:
- Spray the air with a disinfectant 10 minutes before beginning work. This neutralizes charges on colloidal particles, which causes them to fall out of the air.
- Immediately before working, spray surfaces with cleaning solution such as 70% ethanol solution or 80% isopropanol solution.
-
Wipe all surfaces with a clean room tissue or microfiber cloth. Start with the cleanest area and progress to the dirtiest area to avoid spreading contamination. In a vertical laminar flow hood, clean the back wall first. In a horizontal laminar flow hood, clean the ceiling panel first.
- Clean the side walls by moving side to side, from top to bottom.
- Always clean the floor panel last. Repeat the same motion from the back to the front. During this stage, change the cloth or tissue often.
- Do not attempt to clean the filter panel.




General Tips
- You can use different cleaning solutions to clean your laminar flow hood, including IPA, ethanol, and distilled water. The solutions and steps you use should depend on your experiment. The general procedure is to use a 7:3 ethanol to water mix, or a 4:1 IPA to water mix.
- Use several clean microfiber cloths or lint-free, non-shedding clean room tissue. Use a new cloth or tissue for each wall or whenever it looks dirty.
- The entire hood should be cleaned daily. Clean the hood again if any contamination is suspected, after any spills, or before performing a media test.
- Work surfaces should be cleaned before and after every use of the laminar flow hood.
Filter Contamination
If your HEPA filter becomes contaminated, it can quickly contaminate the whole workspace. This makes monitoring the saturation of your filter very important. It is also useful to be aware of any filter contamination risks.
As the filter traps more and more particles, it will become more saturated and less effective. Our laminar flow hood monitors and reports the filter saturation on the display screen. This feature will notify you when the filter needs to be changed.
If the filter has become contaminated (causing contamination of your workspace), you can conduct a sterility experiment to check the integrity of your laminar flow hood.
Is Your Laminar Flow Hood Clean Enough?
Contamination is a risk in any environment. The likelihood of sample contamination occurring inside a laminar flow hood is greatly reduced, but it is not zero. You should periodically check the levels of contamination inside your laminar flow hood. You can also use this technique to find the cleanest areas of your workspace, by placing multiple petri dishes at multiple points inside the hood.
For general testing, peptone agar plates can be used while specific contaminants may require other media to thrive. For example, to test for fungal contamination you can use malt extract agar plates.
To test level of contamination in your laminar flow hood:
- Expose the prepared media plates to the inside of the laminar flow hood for various time intervals. These intervals should be chosen depending on the type and length of experiment you are doing.
- Incubate the petri dishes for 1–3 days
- Count the number of colonies that have grown
Exposure to the workspace begins once the protective lid of the media plate is removed and stops when the lid is placed back on.
Contamination Issues
The test indicates a clean environment if there are no colonies after 1 hour of exposure. You should clean your laminar flow hood thoroughly if colonies grow following exposure. If this doesn't fix your contamination issues, you may need to:
- Replace your HEPA filter
- Replace any sterile materials you are using
- Replace or clean any equipment you have brought into the laminar flow hood
If the test conditions change between the test and your experiment, the results of the test will be void. It is recommended that all required equipment is moved into the flow hood while testing, to identify any contamination from external equipment.
Laminar Flow Hood

Learn More
 Replacing Your Laminar Flow Hood Filter
Replacing Your Laminar Flow Hood Filter
Laminar flow hoods use pre-filters and high efficiency particulate air (HEPA) filters to create an environment with very low levels of contamination. It is important to know when and how to replace these filters, without risking contamination to the environment.
Read more... Getting Started with the Laminar Flow Hood
Getting Started with the Laminar Flow Hood
Ossila laminar flow hoods are designed for effortless setup, user-friendly operation, and efficient control. This short video guide shows you how to get started with your new equipment.
Read more...References
Kawachi, M. et al. (2005) ‘Sterilization and sterile technique’, Algal culturing techniques. doi:10.1016/B978-012088426-1/50006-8